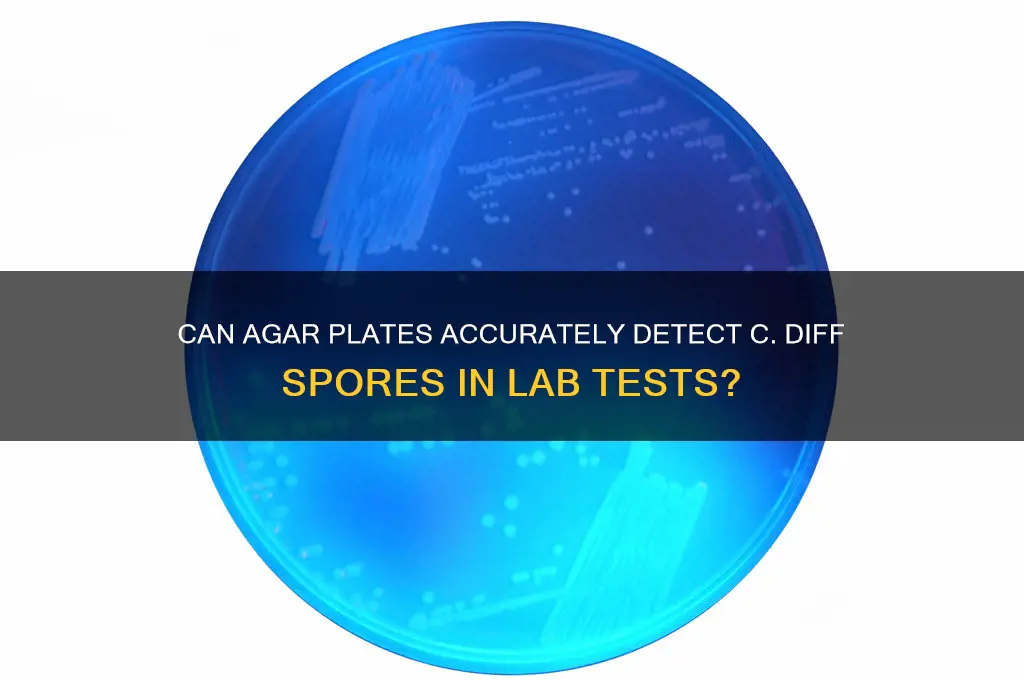
do agar plates detect c diff spores

Agar plates are a fundamental tool in microbiology, widely used for culturing and identifying bacteria. However, their effectiveness in detecting *Clostridioides difficile* (C. diff) spores is limited. C. diff spores are highly resistant to environmental stresses, including the conditions typically used for bacterial culturing on agar plates. Standard agar media may not support the germination and growth of C. diff spores, as they require specific conditions, such as bile salts and certain nutrients, to activate and proliferate. Specialized selective agar media, like cycloserine-cefoxitin-fructose agar (CCFA) or taurocholate-cycloserine-cefoperazone-fructose agar (TCCFA), are often used to enhance detection by inhibiting competing flora and promoting spore germination. Even with these media, additional techniques, such as toxin testing or molecular methods like PCR, are frequently employed to confirm the presence of C. diff, as spores alone may not always indicate active infection. Thus, while agar plates can be part of the detection process, they are not solely sufficient for identifying C. diff spores.
| Characteristics | Values |
|---|---|
| Detection of C. diff Spores | Yes, certain agar plates can detect Clostridioides difficile spores. |
| Recommended Agar Plate | Cycloserine-Cefoxitin-Fructose-Agar (CCFA) or C. difficile Moxalactam Norfloxacin (CDMN) agar. |
| Selective Agents | Cycloserine, cefoxitin, moxalactam, and norfloxacin inhibit non-C. difficile bacteria. |
| Differential Agents | Egg yolk or sodium taurocholate may be added to enhance spore germination. |
| Incubation Conditions | Anaerobic or anaerobic-mimicking conditions (e.g., GasPak jars) at 35-37°C for 48 hours. |
| Appearance of Colonies | Black or mottled black colonies due to iron sulfite reduction. |
| Limitations | May require pre-treatment (e.g., ethanol shock) to enhance spore detection. |
| Sensitivity | High sensitivity for vegetative cells; spore detection may require optimization. |
| Common Use | Clinical diagnosis of C. difficile infection (CDI) from stool samples. |
| Alternative Methods | PCR-based assays or toxin detection for more rapid and sensitive results. |
Explore related products
What You'll Learn

C. diff spore viability on agar plates
C. diff spores present a unique challenge in clinical microbiology due to their resilience and dormancy. Unlike vegetative cells, spores are metabolically inactive and highly resistant to environmental stressors, including heat, desiccation, and antibiotics. When assessing C. diff spore viability on agar plates, it’s critical to understand that standard agar media, such as cycloserine-cefoxitin-fructose agar (CCFA), are primarily designed to detect actively growing vegetative cells, not dormant spores. Spores require specific conditions, such as nutrient availability and temperature shifts, to germinate and revert to the vegetative form, which can then be cultured. Without these triggers, spores may remain undetected on agar plates, leading to false-negative results.
To detect C. diff spores, a two-step process is often employed. First, a spore-specific enrichment step is necessary to encourage germination. This involves incubating the sample in a nutrient-rich broth, such as cooked meat medium or brain heart infusion broth, supplemented with additives like taurocholic acid, which promotes spore germination. After 4–6 hours of incubation at 37°C, the sample is then subcultured onto selective agar plates. This method increases the likelihood of detecting viable spores by forcing them to revert to the culturable vegetative state. Without this enrichment step, spores may remain dormant and undetected, even if present in the sample.
The viability of C. diff spores on agar plates is further complicated by their resistance mechanisms. Spores possess a thick protein coat and an outer exosporium that protect the core DNA and enzymes. These structures make spores impervious to many antimicrobial agents and environmental conditions that would otherwise kill vegetative cells. When spores are directly plated onto agar without prior enrichment, they may fail to germinate due to the lack of specific germinants or suboptimal conditions. For instance, agar plates lacking bile salts or incubated at temperatures outside the optimal range (35–37°C) may inhibit spore activation. This highlights the importance of tailoring culture conditions to the unique biology of C. diff spores.
Practical considerations for detecting C. diff spores include sample handling and incubation time. Stool samples should be processed promptly, as delays can reduce spore viability. If immediate processing is not possible, samples should be stored at 4°C for no more than 24 hours or frozen at -70°C to preserve spore integrity. During incubation, extended periods (up to 48 hours) may be required to allow sufficient time for spore germination and colony growth. Additionally, using anaerobic conditions or anaerobic jars can enhance recovery, as C. diff is an anaerobe. These steps ensure that viable spores are not overlooked during diagnostic testing.
In conclusion, agar plates alone are insufficient for detecting C. diff spores due to their dormant and resilient nature. A combination of enrichment techniques, specific culture conditions, and careful sample handling is essential to ensure accurate detection. Clinicians and laboratory personnel must be aware of these limitations to avoid false-negative results, which could delay diagnosis and treatment of *Clostridioides difficile* infections. By understanding the unique viability requirements of C. diff spores, laboratories can improve detection rates and contribute to better patient outcomes.
Are White Mold Spores Common? Uncovering the Truth About Mold Colors
You may want to see also

Selective media for C. diff detection
Clostridioides difficile (C. diff) spores present a unique challenge in clinical diagnostics due to their hardy nature and the need for selective isolation. Traditional agar plates, while effective for many bacteria, often fall short in detecting C. diff spores directly. This is where selective media steps in as a critical tool, designed to inhibit competing flora while encouraging the growth of C. diff, even in its spore form.
Common selective media for C. diff include cycloserine-cefoxitin-fructose agar (CCFA) and taurocholate-cycloserine-cefotetan-fructose agar (TCCFA). These media leverage key components: cycloserine, which inhibits Gram-positive bacteria, and cefoxitin or cefotetan, which suppress Gram-negative bacteria. The addition of taurocholate, a bile salt, further enhances selectivity by promoting C. diff germination and growth while inhibiting other anaerobes.
The process of using selective media for C. diff detection involves several steps. First, a stool sample is collected from the patient, ideally within 48 hours of symptom onset for optimal sensitivity. The sample is then inoculated onto the selective agar plate and incubated anaerobically at 35-37°C for 48 hours. Following incubation, suspect colonies are identified based on characteristic morphology—typically flat, grayish, and ground-glass appearance. Confirmatory tests, such as toxin detection or molecular assays, are often performed to ensure accuracy.
While selective media are highly effective, they are not without limitations. Overgrowth of non-C. diff bacteria can occasionally occur, leading to false-negative results. Additionally, some C. diff strains may exhibit reduced growth on selective media due to antibiotic resistance or genetic variations. To mitigate these risks, laboratories should adhere to strict protocols, including proper sample handling, accurate incubation conditions, and routine quality control checks.
In conclusion, selective media play a pivotal role in the detection of C. diff spores, offering a targeted approach that enhances diagnostic accuracy. By understanding the composition, application, and limitations of these media, clinicians and laboratory professionals can optimize their efforts in identifying and managing C. diff infections effectively.
Linking Steam and Origin: A Guide to Playing Spore Seamlessly
You may want to see also

Incubation conditions for spore growth
Clostridioides difficile (C. diff) spores present a unique challenge in detection due to their resilient nature. Unlike vegetative cells, spores require specific incubation conditions to germinate and grow into detectable colonies on agar plates. Understanding these conditions is crucial for accurate diagnosis and effective infection control.
Optimizing Temperature and Atmosphere:
C. diff spores germinate optimally at 37°C (98.6°F), mimicking the human body temperature. This temperature facilitates the activation of enzymes necessary for spore outgrowth. Maintaining a anaerobic or microaerophilic environment is equally vital. C. diff is an anaerobic bacterium, meaning it thrives in oxygen-depleted conditions. Specialized anaerobic jars or gas packs can be used to create this environment within the incubator.
Nutrient-Rich Media and Selective Agents:
Standard nutrient agar is insufficient for reliable C. diff spore detection. Selective agar media like cycloserine-cefoxitin-fructose agar (CCFA) or taurocholate-cycloserine-cefoperazone-fructose (TCCFA) are essential. These media contain antibiotics and bile salts that inhibit the growth of most competing bacteria while promoting C. diff growth. Taurocholate, a bile salt, acts as a germinant, triggering spore activation.
Incubation Duration and Monitoring:
Incubation times typically range from 48 to 72 hours. However, some spores may require extended incubation periods, especially if the sample contains a low spore burden. Regularly inspecting plates for characteristic C. diff colonies (grayish, ground-glass appearance) is crucial.
Challenges and Considerations:
Despite optimized conditions, detecting C. diff spores can be challenging. Spores may remain dormant even under favorable conditions, leading to false-negative results. Additionally, some strains exhibit variable germination requirements, necessitating further research and potentially tailored incubation protocols.
Unveiling the Ploidy of Spirogyra Filament Spores: Haploid or Diploid?
You may want to see also
Explore related products

Differentiating C. diff spores from vegetative cells
C. diff spores and vegetative cells exhibit distinct characteristics that necessitate different detection strategies. Spores, the dormant form of *Clostridioides difficile*, are highly resistant to environmental stresses, including heat, desiccation, and many disinfectants. In contrast, vegetative cells are metabolically active but more susceptible to destruction. This fundamental difference in resilience means that standard agar plates, while effective for culturing vegetative cells, often fail to detect spores directly. Spores require specific conditions, such as heat shock or prolonged incubation, to germinate into vegetative cells before they can grow on agar.
To differentiate between spores and vegetative cells, laboratories employ targeted techniques. One common method is the ethanol shock treatment, where a sample is exposed to 95% ethanol for 30 minutes. Vegetative cells are killed by this treatment, while spores remain viable. The treated sample is then cultured on selective agar, such as cycloserine-cefoxitin-fructose agar (CCFA), to detect germinated spores. Another approach is spore staining, using dyes like malachite green, which penetrate the spore’s thick coat, distinguishing them from vegetative cells under microscopy. These methods highlight the need for specialized protocols to identify spores, as conventional agar plates alone are insufficient.
From a practical standpoint, differentiating spores from vegetative cells is critical in clinical and environmental settings. For instance, in healthcare facilities, detecting spores is essential for assessing contamination risks, as spores can persist on surfaces for months. In contrast, vegetative cells are more relevant in diagnosing active infections, as they produce toxins responsible for symptoms like diarrhea. Laboratories must tailor their detection strategies based on the form of *C. diff* they aim to identify, ensuring accurate results and appropriate interventions.
A comparative analysis reveals that while vegetative cells are easier to culture on standard agar plates, spores demand additional steps. For example, incorporating a heat shock step at 65°C for 10 minutes before plating can enhance spore germination. Alternatively, using spore-specific PCR assays can directly detect spore DNA without relying on germination. These techniques underscore the importance of understanding the unique biology of spores and vegetative cells to optimize detection methods.
In conclusion, differentiating *C. diff* spores from vegetative cells requires a nuanced approach that goes beyond standard agar plate culture. By leveraging techniques like ethanol shock, spore staining, and PCR assays, laboratories can accurately identify both forms, ensuring comprehensive detection in clinical and environmental contexts. This distinction is not merely academic but has practical implications for infection control, treatment, and prevention strategies.
Aspirating Fungal Spores from Adherent Cells: Techniques and Considerations
You may want to see also

Limitations of agar plates in spore detection
Agar plates, while widely used in microbiology, face significant limitations when it comes to detecting *Clostridioides difficile* (C. diff) spores. One major issue is the sporulation state of C. diff. Spores are metabolically dormant and require specific conditions to germinate into vegetative cells, which are then detectable on agar. Standard agar plates often lack the necessary germinants like bile acids or specific amino acids, leading to false-negative results. For instance, a study in *Journal of Clinical Microbiology* found that without supplementation, agar plates missed up to 30% of C. diff spores in clinical samples.
Another limitation lies in the selectivity of agar plates. C. diff spores are notoriously difficult to isolate due to their sensitivity to oxygen and the presence of competing microorganisms. Traditional agar formulations, such as cycloserine-cefoxitin-fructose agar (CCFA), may fail to suppress non-C. diff flora effectively, especially in complex samples like stool. This can result in overgrown plates or missed detections. Researchers often recommend anaerobic incubation and pre-treatment steps like ethanol shock to enhance spore recovery, but these add complexity and time to the process.
The quantitative accuracy of agar plates is also questionable for spore detection. Spores are typically present in low numbers compared to vegetative cells, and agar plates lack the sensitivity to reliably detect small quantities. Molecular methods like PCR, which amplify DNA, offer far greater sensitivity, detecting as few as 10 spores per gram of stool. In contrast, agar plates often require higher spore concentrations (e.g., 10^3–10^4 CFU/g) for visible colonies, making them less suitable for early or low-burden infections.
Practically, the time-to-result for agar plates is a significant drawback. C. diff spores can take up to 48–72 hours to form visible colonies, even under optimal conditions. This delay contrasts sharply with rapid diagnostic tools like toxin assays or PCR, which provide results in hours. For clinicians managing suspected C. diff infections, this lag can hinder timely treatment decisions, particularly in critically ill patients where rapid intervention is crucial.
In conclusion, while agar plates remain a cornerstone of microbiology, their limitations in detecting C. diff spores are clear. From sporulation requirements to selectivity issues, quantitative inaccuracies, and slow turnaround times, these challenges underscore the need for complementary methods. For reliable spore detection, laboratories should consider integrating molecular techniques or spore-specific enrichment protocols alongside traditional agar-based approaches.
Are Ivy Spores Harmful? Uncovering the Truth About Ivy Spores
You may want to see also
Frequently asked questions
Yes, agar plates, particularly those with selective media like cycloserine-cefoxitin-fructose (CCFA) agar, can detect *Clostridioides difficile* (C. diff) spores. The spores will grow into colonies on the agar, allowing for identification.
Agar plates do not inherently differentiate between C. diff spores and vegetative cells. Both forms can grow on selective media, but additional tests, such as spore staining or PCR, are needed to specifically identify spores.
While agar plates are effective for detecting C. diff, they are not the most reliable method for specifically identifying spores. Molecular techniques like PCR or spore-specific assays are more accurate for detecting spores in clinical samples.























